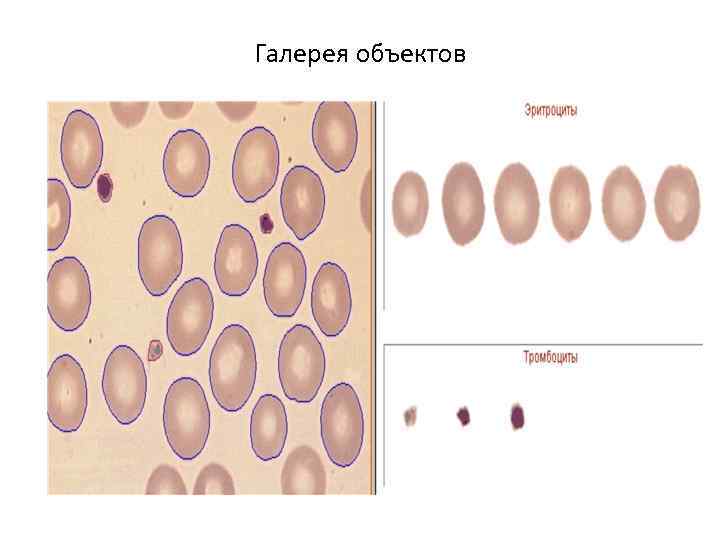
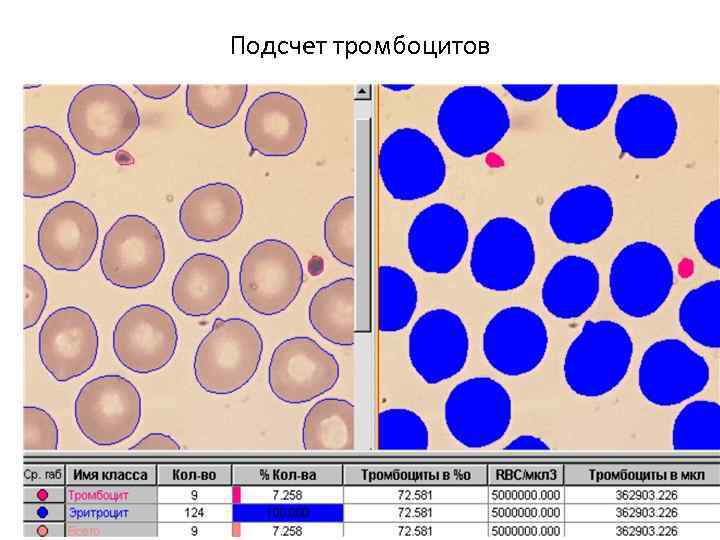

prakt_r__3_metodi_issled_kletok.ppt
- Количество слайдов: 29
 Методы изучения клетки Световой Электронной Фракциони- Рентгенострук- Клеточных Микрохирургии Слияние клеток микроскопии рования турного анализа культур светлого темного Дифференциаль- поля и его реплик ное центрифуги- Метод Лауэ разновидности рование Поляризацион- Зональное Метод фазового Метод ная декорирования центрифуги- контраста Дебая-Шеррера микроскопия рование Наблюдение в наблюдения в Амплитудная инфракрасных Ультрафиолето- электронная лучах вых лучах микроскопия Микрофотогра- Интерференцион- Фазовая фирование и ного контраста Электронная икрокиносъёмка микроскопия исследования Лоренцова в свете электронная юминесценции микроскопия Количественная Электронная микроскопия
Методы изучения клетки Световой Электронной Фракциони- Рентгенострук- Клеточных Микрохирургии Слияние клеток микроскопии рования турного анализа культур светлого темного Дифференциаль- поля и его реплик ное центрифуги- Метод Лауэ разновидности рование Поляризацион- Зональное Метод фазового Метод ная декорирования центрифуги- контраста Дебая-Шеррера микроскопия рование Наблюдение в наблюдения в Амплитудная инфракрасных Ультрафиолето- электронная лучах вых лучах микроскопия Микрофотогра- Интерференцион- Фазовая фирование и ного контраста Электронная икрокиносъёмка микроскопия исследования Лоренцова в свете электронная юминесценции микроскопия Количественная Электронная микроскопия
 Метод световой микроскопии Методы микроскопии выбираются (и обеспечиваются конструктивно) в зависимости от характера и свойств изучаемых объектов, так как последние влияют на контрастность изображения.
Метод световой микроскопии Методы микроскопии выбираются (и обеспечиваются конструктивно) в зависимости от характера и свойств изучаемых объектов, так как последние влияют на контрастность изображения.
 Метод светлого поля и его разновидности Метод светлого поля в проходящем свете применяется при изучении прозрачных препаратов с включенными в них абсорбирующими (поглощающими свет) частицами и деталями. Это могут быть, например, тонкие окрашенные срезы животных и растительных тканей, тонкие шлифы минералов и т. д. В отсутствие препарата пучок света из конденсора, проходя через объектив, даёт вблизи фокальной плоскости окуляра равномерно освещенное поле. При наличии в препарате абсорбирующего элемента происходит частичное поглощение и частичное рассеивание падающего. На него света, что и обусловливает появление изображения. Метод косого освещения - разновидность предыдущего метода. Отличие между ними состоит в том, что свет на объект направляют под большим углом к направлению наблюдения. Иногда это помогает выявить «рельефность» объекта за счёт образования теней. Метод светлого поля в отражённом свете применяется при исследовании непрозрачных отражающих свет объектов, например шлифов металлов или руд. Освещение препарата (от осветителя и полупрозрачного зеркала) производится сверху, через объектив, который одновременно играет и роль конденсора. В изображении, создаваемом в плоскости объективом совместно с тубусной линзой, структура препарата видна из-за различия в отражающей способности её элементов; на светлом поле выделяются также неоднородности, рассеивающие падающий на них свет.
Метод светлого поля и его разновидности Метод светлого поля в проходящем свете применяется при изучении прозрачных препаратов с включенными в них абсорбирующими (поглощающими свет) частицами и деталями. Это могут быть, например, тонкие окрашенные срезы животных и растительных тканей, тонкие шлифы минералов и т. д. В отсутствие препарата пучок света из конденсора, проходя через объектив, даёт вблизи фокальной плоскости окуляра равномерно освещенное поле. При наличии в препарате абсорбирующего элемента происходит частичное поглощение и частичное рассеивание падающего. На него света, что и обусловливает появление изображения. Метод косого освещения - разновидность предыдущего метода. Отличие между ними состоит в том, что свет на объект направляют под большим углом к направлению наблюдения. Иногда это помогает выявить «рельефность» объекта за счёт образования теней. Метод светлого поля в отражённом свете применяется при исследовании непрозрачных отражающих свет объектов, например шлифов металлов или руд. Освещение препарата (от осветителя и полупрозрачного зеркала) производится сверху, через объектив, который одновременно играет и роль конденсора. В изображении, создаваемом в плоскости объективом совместно с тубусной линзой, структура препарата видна из-за различия в отражающей способности её элементов; на светлом поле выделяются также неоднородности, рассеивающие падающий на них свет.
 Метод темного поля и его разновидности Метод тёмного поля в проходящем свете используется для получения изображений прозрачных неабсорбирующих объектов, которые не могут быть видны, если применить метод светлого поля. В темнопольном микроскопе свет падает косыми лучами света и здесь , когда структуры становятся видными благодаря их резкому свечению на темном фоне. Метод может применяться для изучения живых клеток. Зачастую это биологические объекты. Свет от осветителя и зеркала направляется на препарат конденсором специальной конструкции — т. н. конденсором тёмного поля. По выходе из конденсора основная часть лучей света, не изменившая своего направления при прохождении через прозрачный препарат, образует пучок в виде полого конуса и не попадает в объектив (который находится внутри этого конуса). Изображение в микроскопе формируется при помощи лишь небольшой части лучей, рассеянных микрочастицами находящегося на предметном стекле препарата внутрь конуса и прошедшими через объектив. В поле зрения на тёмном фоне видны светлые изображения элементов структуры препарата, отличающихся от окружающей среды показателем преломления. У крупных частиц видны только светлые края, рассеивающие лучи света. Используя этот метод, нельзя определить по виду изображения, прозрачны частицы или непрозрачны, больший или меньший показатель преломления они имеют по сравнению с окружающей средой.
Метод темного поля и его разновидности Метод тёмного поля в проходящем свете используется для получения изображений прозрачных неабсорбирующих объектов, которые не могут быть видны, если применить метод светлого поля. В темнопольном микроскопе свет падает косыми лучами света и здесь , когда структуры становятся видными благодаря их резкому свечению на темном фоне. Метод может применяться для изучения живых клеток. Зачастую это биологические объекты. Свет от осветителя и зеркала направляется на препарат конденсором специальной конструкции — т. н. конденсором тёмного поля. По выходе из конденсора основная часть лучей света, не изменившая своего направления при прохождении через прозрачный препарат, образует пучок в виде полого конуса и не попадает в объектив (который находится внутри этого конуса). Изображение в микроскопе формируется при помощи лишь небольшой части лучей, рассеянных микрочастицами находящегося на предметном стекле препарата внутрь конуса и прошедшими через объектив. В поле зрения на тёмном фоне видны светлые изображения элементов структуры препарата, отличающихся от окружающей среды показателем преломления. У крупных частиц видны только светлые края, рассеивающие лучи света. Используя этот метод, нельзя определить по виду изображения, прозрачны частицы или непрозрачны, больший или меньший показатель преломления они имеют по сравнению с окружающей средой.
 Поляризационная микроскопия В основе метода поляризационной микроскопии лежит способность разных компонентов клетки преломлять поляризуемый свет, что дает возможность выявлять одиночное и двойное преломление световых лучей. Используется при изучении миофибрилл, коллагеновых волокон и тому подобное
Поляризационная микроскопия В основе метода поляризационной микроскопии лежит способность разных компонентов клетки преломлять поляризуемый свет, что дает возможность выявлять одиночное и двойное преломление световых лучей. Используется при изучении миофибрилл, коллагеновых волокон и тому подобное
 Фазово-контрастная микроскопия. Используют для получения четкого изображения прозрачных и бесцветных объектов, невидимых при обычных методах микроскопии. Для изучения препаратов в обычном световом микроскопе необходимая контрастность структур достигается с помощью окрашивания препаратов. Метод фазового контраста обеспечивает необходимую контрастность изучаемых неокрашенных структур за счет специальной кольцевой диафрагмы, помещаемой в конденсаторе и так называемой фазовой пластинки, находящейся в объективе. В фазовоконтрастном микроскопе используется явление дифракции. С помощью кольцевой диафрагмы “фазовой пластинки” повышается контрастность объекта, что дает возможность различать структуры, которые имеют разные показатели преломления. Применяется такой микроскоп для изучения живых объектов без их фиксации и окрашивания
Фазово-контрастная микроскопия. Используют для получения четкого изображения прозрачных и бесцветных объектов, невидимых при обычных методах микроскопии. Для изучения препаратов в обычном световом микроскопе необходимая контрастность структур достигается с помощью окрашивания препаратов. Метод фазового контраста обеспечивает необходимую контрастность изучаемых неокрашенных структур за счет специальной кольцевой диафрагмы, помещаемой в конденсаторе и так называемой фазовой пластинки, находящейся в объективе. В фазовоконтрастном микроскопе используется явление дифракции. С помощью кольцевой диафрагмы “фазовой пластинки” повышается контрастность объекта, что дает возможность различать структуры, которые имеют разные показатели преломления. Применяется такой микроскоп для изучения живых объектов без их фиксации и окрашивания
 Метод наблюдения в инфракрасных лучах • Метод наблюдения в инфракрасных (ИК) лучах также требует преобразования невидимого для глаза изображения в видимое с использованием фотографирования или с помощью электронно- оптического преобразователя. ИК микроскопия дает возможность изучать внутреннюю структуру тех объектов, которые непрозрачны в видимом свете, например тёмных стекол, некоторых кристаллов и минералов и пр
Метод наблюдения в инфракрасных лучах • Метод наблюдения в инфракрасных (ИК) лучах также требует преобразования невидимого для глаза изображения в видимое с использованием фотографирования или с помощью электронно- оптического преобразователя. ИК микроскопия дает возможность изучать внутреннюю структуру тех объектов, которые непрозрачны в видимом свете, например тёмных стекол, некоторых кристаллов и минералов и пр
 Метод наблюдения в ультрафиолетовых лучах • Метод наблюдения в ультрафиолетовых (УФ) лучах делает возможным увеличение предельной разрешающей способности микроскопа. Главное преимущество метода состоит в том, что частицы многих веществ, прозрачные в видимом свете, сильно поглощают УФ излучение определённых длин волн и, следовательно, легко различимы в УФ изображениях. Характерными спектрами поглощения в УФ области обладают многие вещества, содержащиеся в растительных и животных клетках (пуриновые основания, пиримидиновые основания, большинство витаминов, ароматические аминокислоты, некоторые липиды, тироксин и др. ). • Так как ультрафиолетовые лучи невидимы для человеческого глаза, то изображения в УФ микроскопии регистрируют либо фотографически, либо с помощью электронно-оптического преобразователя или люминесцирующего экрана. Препарат фотографируется в трёх длинах волн УФ области спектра. Каждый из полученных негативов освещается видимым светом определённого цвета (например, синим, зелёным и красным), и все они одновременно проектируются на один экран. Результат – цветное изображение объекта в условных цветах, зависящих от поглощающей способности препарата в ультрафиолете.
Метод наблюдения в ультрафиолетовых лучах • Метод наблюдения в ультрафиолетовых (УФ) лучах делает возможным увеличение предельной разрешающей способности микроскопа. Главное преимущество метода состоит в том, что частицы многих веществ, прозрачные в видимом свете, сильно поглощают УФ излучение определённых длин волн и, следовательно, легко различимы в УФ изображениях. Характерными спектрами поглощения в УФ области обладают многие вещества, содержащиеся в растительных и животных клетках (пуриновые основания, пиримидиновые основания, большинство витаминов, ароматические аминокислоты, некоторые липиды, тироксин и др. ). • Так как ультрафиолетовые лучи невидимы для человеческого глаза, то изображения в УФ микроскопии регистрируют либо фотографически, либо с помощью электронно-оптического преобразователя или люминесцирующего экрана. Препарат фотографируется в трёх длинах волн УФ области спектра. Каждый из полученных негативов освещается видимым светом определённого цвета (например, синим, зелёным и красным), и все они одновременно проектируются на один экран. Результат – цветное изображение объекта в условных цветах, зависящих от поглощающей способности препарата в ультрафиолете.
 Микрофотографирование и микрокиносъёмка Микрофотографирование и микрокиносъёмка – это получение с помощью микроскопа изображений на светочувствительных слоях. Данный метод широко применяется совместно со всеми другими методами микроскопического исследования. Для микрофото- и микрокиносъёмки требуется некоторая перестройка оптической системы микроскопа — иная по сравнению с визуальным наблюдением фокусировки окуляра относительно изображения, даваемого объективом. Микрофотография необходима при документировании исследований, при изучении объектов в невидимых для глаза УФ и ИК лучах (см. выше), а также объектов со слабой интенсивностью свечения. Микрокиносъёмка незаменима при исследовании процессов, развёртывающихся во времени (жизнедеятельности тканевых клеток и микроорганизмов, роста кристаллов, протекания простейших химических реакций и т. п. ).
Микрофотографирование и микрокиносъёмка Микрофотографирование и микрокиносъёмка – это получение с помощью микроскопа изображений на светочувствительных слоях. Данный метод широко применяется совместно со всеми другими методами микроскопического исследования. Для микрофото- и микрокиносъёмки требуется некоторая перестройка оптической системы микроскопа — иная по сравнению с визуальным наблюдением фокусировки окуляра относительно изображения, даваемого объективом. Микрофотография необходима при документировании исследований, при изучении объектов в невидимых для глаза УФ и ИК лучах (см. выше), а также объектов со слабой интенсивностью свечения. Микрокиносъёмка незаменима при исследовании процессов, развёртывающихся во времени (жизнедеятельности тканевых клеток и микроорганизмов, роста кристаллов, протекания простейших химических реакций и т. п. ).
 Автоматический микроскоп-анализатор
Автоматический микроскоп-анализатор
Галерея объектов
Галерея объектов
 Методика «Эритроцитометрия»
Методика «Эритроцитометрия»
 Диаграмма эритроцитов
Диаграмма эритроцитов
Подсчет тромбоцитов
Подсчет тромбоцитов
 Метод интерференционного контраста Метод интерференционного контраста (интерференционная микроскопия) состоит в том, что каждый луч раздваивается, входя в микроскоп. Один из полученных лучей направляется сквозь наблюдаемую частицу, другой — мимо неё по той же или дополнительной оптической ветви микроскопа. В окулярной части микроскопа оба луча вновь соединяются и интерферируют между собой. Конденсор и объектив снабжены двояко-преломляющими пластинками, из которых первая расщепляет исходный световой луч на два луча, а вторая воссоединяет их. Один из лучей, проходя через объект, запаздывает по фазе (приобретает разность хода по сравнению со вторым лучом). Величина этого запаздывания измеряется компенсатором. Этот метод дает возможность наблюдать прозрачные и бесцветные объекты, но их изображения могут быть и разноцветными (интерференционные цвета). Этот метод пригоден для изучения живых тканей и клеток и применяется во многих случаях именно с этой целью. Метод интерференционного контраста часто применяют совместно с другими методами микроскопии, в частности с наблюдением в поляризованном свете. Его применение в сочетании с микроскопией в ультрафиолетовых лучах позволяет, к примеру, определить содержание нуклеиновых кислот в общей сухой массе объекта.
Метод интерференционного контраста Метод интерференционного контраста (интерференционная микроскопия) состоит в том, что каждый луч раздваивается, входя в микроскоп. Один из полученных лучей направляется сквозь наблюдаемую частицу, другой — мимо неё по той же или дополнительной оптической ветви микроскопа. В окулярной части микроскопа оба луча вновь соединяются и интерферируют между собой. Конденсор и объектив снабжены двояко-преломляющими пластинками, из которых первая расщепляет исходный световой луч на два луча, а вторая воссоединяет их. Один из лучей, проходя через объект, запаздывает по фазе (приобретает разность хода по сравнению со вторым лучом). Величина этого запаздывания измеряется компенсатором. Этот метод дает возможность наблюдать прозрачные и бесцветные объекты, но их изображения могут быть и разноцветными (интерференционные цвета). Этот метод пригоден для изучения живых тканей и клеток и применяется во многих случаях именно с этой целью. Метод интерференционного контраста часто применяют совместно с другими методами микроскопии, в частности с наблюдением в поляризованном свете. Его применение в сочетании с микроскопией в ультрафиолетовых лучах позволяет, к примеру, определить содержание нуклеиновых кислот в общей сухой массе объекта.
 Метод исследования в свете люминесценции Метод исследования в свете люминесценции состоит в наблюдении под микроскопом зелено-оранжевого свечения микрообъектов, которое возникает при их освещении сине-фиолетовым светом или не видимыми глазом ультрафиолетовыми лучами. В оптическую схему микроскопа вводятся два светофильтра. Один из них помещают перед конденсором. Он пропускает от источника-осветителя излучение только тех длин волн, которые возбуждают люминесценцию либо самого объекта (собственная люминесценция), либо специальных красителей, введённых в препарат и поглощённых его частицами (вторичная люминесценция). Второй светофильтр, который установлен после объектива, пропускает к глазу наблюдателя (или на фоточувствительный слой) только свет люминесценции. В люминесцентной микроскопии используют освещение препаратов как сверху (через объектив, который в этом случае служит и конденсором), так и снизу, через обычный конденсор. Метод нашел широкое применение в микробиологии, вирусологии, гистологии, цитологии, в пищевой промышленности, при исследовании почв, в микрохимическом анализе, в дефектоскопии. Такое многообразие применений объясняется очень высокой цветовой чувствительностью глаза и высокой контрастностью изображения самосветящегося объекта на тёмном не люминесцирующем фоне.
Метод исследования в свете люминесценции Метод исследования в свете люминесценции состоит в наблюдении под микроскопом зелено-оранжевого свечения микрообъектов, которое возникает при их освещении сине-фиолетовым светом или не видимыми глазом ультрафиолетовыми лучами. В оптическую схему микроскопа вводятся два светофильтра. Один из них помещают перед конденсором. Он пропускает от источника-осветителя излучение только тех длин волн, которые возбуждают люминесценцию либо самого объекта (собственная люминесценция), либо специальных красителей, введённых в препарат и поглощённых его частицами (вторичная люминесценция). Второй светофильтр, который установлен после объектива, пропускает к глазу наблюдателя (или на фоточувствительный слой) только свет люминесценции. В люминесцентной микроскопии используют освещение препаратов как сверху (через объектив, который в этом случае служит и конденсором), так и снизу, через обычный конденсор. Метод нашел широкое применение в микробиологии, вирусологии, гистологии, цитологии, в пищевой промышленности, при исследовании почв, в микрохимическом анализе, в дефектоскопии. Такое многообразие применений объясняется очень высокой цветовой чувствительностью глаза и высокой контрастностью изображения самосветящегося объекта на тёмном не люминесцирующем фоне.
 Методы электронной микроскопии Метод Амплитудная Фазовая Метод реплик декорирования электронная микроскопия Лоренцова Количественная электронная электронная микроскопия микроскопия
Методы электронной микроскопии Метод Амплитудная Фазовая Метод реплик декорирования электронная микроскопия Лоренцова Количественная электронная электронная микроскопия микроскопия
 Метод реплик • Метод реплик используют для изучения поверхностной геометрической структуры массивных тел. С поверхности такого тела снимается отпечаток в виде тонкой плёнки углерода, коллодия и др. , повторяющий рельеф поверхности и рассматривается в просвечивающем электронном микроскопе. Обычно предварительно под скользящим (малым к поверхности) углом на реплику в вакууме напыляется слой сильно рассеивающего электроны тяжёлого металла, оттеняющего выступы и впадины геометрического рельефа.
Метод реплик • Метод реплик используют для изучения поверхностной геометрической структуры массивных тел. С поверхности такого тела снимается отпечаток в виде тонкой плёнки углерода, коллодия и др. , повторяющий рельеф поверхности и рассматривается в просвечивающем электронном микроскопе. Обычно предварительно под скользящим (малым к поверхности) углом на реплику в вакууме напыляется слой сильно рассеивающего электроны тяжёлого металла, оттеняющего выступы и впадины геометрического рельефа.
 Метод декорирования • Метод декорирования исследует не только геометрическую структуру поверхностей, но и микрополя, обусловленные наличием дислокаций, скопления точечных дефектов, ступени роста кристаллических граней, доменную структуру и т. д. . Согласно этому методу на поверхность образца вначале напыляется очень тонкий слой декорирующих частиц (атомы Au, Pt и др. , молекулы полупроводников или диэлектриков), осаждающихся преимущественно на участках сосредоточения микрополей, а затем снимается реплика с включениями декорирующих частиц.
Метод декорирования • Метод декорирования исследует не только геометрическую структуру поверхностей, но и микрополя, обусловленные наличием дислокаций, скопления точечных дефектов, ступени роста кристаллических граней, доменную структуру и т. д. . Согласно этому методу на поверхность образца вначале напыляется очень тонкий слой декорирующих частиц (атомы Au, Pt и др. , молекулы полупроводников или диэлектриков), осаждающихся преимущественно на участках сосредоточения микрополей, а затем снимается реплика с включениями декорирующих частиц.
 Амплитудная электронная микроскопия • Методы амплитудной электронной микроскопии могут быть использованы для обработки изображений аморфных и других тел (размеры частиц которых меньше разрешаемого в электронном микроскопе расстояния), рассеивающих электроны диффузно. В просвечивающем электронном микроскопе, например, контраст изображения, т. е. перепад яркостей изображения соседних участков объекта, в первом приближении пропорционален перепаду толщин этих участков.
Амплитудная электронная микроскопия • Методы амплитудной электронной микроскопии могут быть использованы для обработки изображений аморфных и других тел (размеры частиц которых меньше разрешаемого в электронном микроскопе расстояния), рассеивающих электроны диффузно. В просвечивающем электронном микроскопе, например, контраст изображения, т. е. перепад яркостей изображения соседних участков объекта, в первом приближении пропорционален перепаду толщин этих участков.
 Фазовая электронная микроскопия • Для расчёта контраста изображений кристаллических тел, имеющих регулярные структуры, а также для решения обратной задачи — расчёта структуры объекта по наблюдаемому изображению — применяются методы фазовой электронной микроскопии. Рассматривается задача о дифракции электронной волны на кристаллической решетке, при решении которой дополнительно учитываются неупругие взаимодействия электронов с объектом: рассеяние на плазмах и т. п. В просвечивающих электронных микроскопах и растровых просвечивающих электронных микроскопах высокого разрешения получают изображения отдельных молекул или атомов тяжелых элементов. Привлекая методы фазовой электронной микроскопии, можно восстанавливать по изображениям трехмерную структуру кристаллов и биологических макромолекул.
Фазовая электронная микроскопия • Для расчёта контраста изображений кристаллических тел, имеющих регулярные структуры, а также для решения обратной задачи — расчёта структуры объекта по наблюдаемому изображению — применяются методы фазовой электронной микроскопии. Рассматривается задача о дифракции электронной волны на кристаллической решетке, при решении которой дополнительно учитываются неупругие взаимодействия электронов с объектом: рассеяние на плазмах и т. п. В просвечивающих электронных микроскопах и растровых просвечивающих электронных микроскопах высокого разрешения получают изображения отдельных молекул или атомов тяжелых элементов. Привлекая методы фазовой электронной микроскопии, можно восстанавливать по изображениям трехмерную структуру кристаллов и биологических макромолекул.
 Количественная электронная микроскопия • Методы количественной электронной микроскопии — это точное измерение различных параметров образца или исследуемого процесса, например измерение локальных электрических потенциалов, магнитных полей, микрогеометрии поверхностного рельефа и т. д. • Лоренцова электронная микроскопия • Областью исследования Лоренцовой электронной микроскопии, в которой изучают явления, обусловленные силой Лоренца, являются внутренние магнитные и электрические поля или внешние поля рассеяния, например, поля магнитных доменов в тонких пленках, сегнетоэлектрических доменов, поля головок для магнитной записи информации и т. п.
Количественная электронная микроскопия • Методы количественной электронной микроскопии — это точное измерение различных параметров образца или исследуемого процесса, например измерение локальных электрических потенциалов, магнитных полей, микрогеометрии поверхностного рельефа и т. д. • Лоренцова электронная микроскопия • Областью исследования Лоренцовой электронной микроскопии, в которой изучают явления, обусловленные силой Лоренца, являются внутренние магнитные и электрические поля или внешние поля рассеяния, например, поля магнитных доменов в тонких пленках, сегнетоэлектрических доменов, поля головок для магнитной записи информации и т. п.
 Методы фракционирования Зональное Дифференциальное центрифугирование Для получения клеточных фракций широко применяются различные виды центрифугирования: дифференциальное центрифугирование, зональное центрифугирование и равновесное центрифугирование в градиенте плотности.
Методы фракционирования Зональное Дифференциальное центрифугирование Для получения клеточных фракций широко применяются различные виды центрифугирования: дифференциальное центрифугирование, зональное центрифугирование и равновесное центрифугирование в градиенте плотности.
 Дифференциальное центрифугирование • В случае дифференциального центрифугирования образцы центрифугируют определенное время при заданной скорости, после чего удаляют надосадочную жидкость. Этот метод полезен для разделения частиц, сильно различающихся по скорости седиментации. Например, центрифугирование в течение 5— 10 мин при 3000— 5000 об/мин приводит к осаждению интактных бактериальных клеток, тогда как большинство клеточных фрагментов при этом остается в надосадочной жидкости. Фрагменты клеточной стенки и большие мембранные структуры можно осадить центрифугированием при 20 000 — 50 000 об/мин в течение 20 мин, в то время как маленькие мембранные везикулы и рибосомы требуют для осаждения центрифугирования при 200 000 об/мин в течение 1 ч.
Дифференциальное центрифугирование • В случае дифференциального центрифугирования образцы центрифугируют определенное время при заданной скорости, после чего удаляют надосадочную жидкость. Этот метод полезен для разделения частиц, сильно различающихся по скорости седиментации. Например, центрифугирование в течение 5— 10 мин при 3000— 5000 об/мин приводит к осаждению интактных бактериальных клеток, тогда как большинство клеточных фрагментов при этом остается в надосадочной жидкости. Фрагменты клеточной стенки и большие мембранные структуры можно осадить центрифугированием при 20 000 — 50 000 об/мин в течение 20 мин, в то время как маленькие мембранные везикулы и рибосомы требуют для осаждения центрифугирования при 200 000 об/мин в течение 1 ч.
 Зональное центрифугирование • Зональное центрифугирование представляет собой эффективный способ разделения структур, имеющих сходную плавучую плотность, но различающихся по форме и массе частиц. В качестве примеров можно привести разделение субъединиц рибосом, различных классов полисом, а также молекул ДНК, имеющих различную форму. Центрифугирование осуществляют либо в бакет-роторах, либо в специально устроенных зональных роторах; для предотвращения конвекции при центрифугировании в стаканах бакет-ротора или в камере зонального ротора создают слабый градиент (обычно сахарозы). Пробу наносят в виде зоны или узкой полосы в самом верху градиентного столбика. Для субклеточных частиц обычно используется градиент сахарозы от 15 до 40% (вес/объем).
Зональное центрифугирование • Зональное центрифугирование представляет собой эффективный способ разделения структур, имеющих сходную плавучую плотность, но различающихся по форме и массе частиц. В качестве примеров можно привести разделение субъединиц рибосом, различных классов полисом, а также молекул ДНК, имеющих различную форму. Центрифугирование осуществляют либо в бакет-роторах, либо в специально устроенных зональных роторах; для предотвращения конвекции при центрифугировании в стаканах бакет-ротора или в камере зонального ротора создают слабый градиент (обычно сахарозы). Пробу наносят в виде зоны или узкой полосы в самом верху градиентного столбика. Для субклеточных частиц обычно используется градиент сахарозы от 15 до 40% (вес/объем).
 Метод клеточных культур • Некоторые ткани удается разделить на отдельные клетки так, что клетки при этом остаются живыми и часто способны к размножению. Этот факт окончательно подтверждает представление о клетке как единице живого. Губку, примитивный многоклеточный организм, можно разделить на клетки путем протирания сквозь сито. Через некоторое время эти клетки вновь соединяются и образуют губку. Эмбриональные ткани животных можно заставить диссоциировать с помощью ферментов или другими способами, ослабляющими связи между клетками. • Американский эмбриолог Р. Гаррисон (1879– 1959) первым показал, что эмбриональные и даже некоторые зрелые клетки могут расти и размножаться вне тела в подходящей среде. Эта техника, называемая культивированием клеток, была доведена до совершенства французским биологом А. Каррелем (1873– 1959). Растительные клетки тоже можно выращивать в культуре, однако по сравнению с животными клетками они образуют большие скопления и прочнее прикрепляются друг к другу, поэтому в процессе роста культуры образуются ткани, а не отдельные клетки. В клеточной культуре из отдельной клетки можно вырастить целое взрослое растение, например морковь.
Метод клеточных культур • Некоторые ткани удается разделить на отдельные клетки так, что клетки при этом остаются живыми и часто способны к размножению. Этот факт окончательно подтверждает представление о клетке как единице живого. Губку, примитивный многоклеточный организм, можно разделить на клетки путем протирания сквозь сито. Через некоторое время эти клетки вновь соединяются и образуют губку. Эмбриональные ткани животных можно заставить диссоциировать с помощью ферментов или другими способами, ослабляющими связи между клетками. • Американский эмбриолог Р. Гаррисон (1879– 1959) первым показал, что эмбриональные и даже некоторые зрелые клетки могут расти и размножаться вне тела в подходящей среде. Эта техника, называемая культивированием клеток, была доведена до совершенства французским биологом А. Каррелем (1873– 1959). Растительные клетки тоже можно выращивать в культуре, однако по сравнению с животными клетками они образуют большие скопления и прочнее прикрепляются друг к другу, поэтому в процессе роста культуры образуются ткани, а не отдельные клетки. В клеточной культуре из отдельной клетки можно вырастить целое взрослое растение, например морковь.
 Метод микрохирургии • С помощью микроманипулятора отдельные части клетки можно удалять, добавлять или каким-то образом видоизменять. Крупную клетку амебы удается разделить на три основных компонента – клеточную мембрану, цитоплазму и ядро, а затем эти компоненты можно вновь собрать и получить живую клетку. Таким путем могут быть получены искусственные клетки, состоящие из компонентов разных видов амеб. • Если принять во внимание, что некоторые клеточные компоненты представляется возможным синтезировать искусственно, то опыты по сборке искусственных клеток могут оказаться первым шагом на пути к созданию в лабораторных условиях новых форм жизни. Поскольку каждый организм развивается из одной единственной клетки, метод получения искусственных клеток в принципе позволяет конструировать организмы заданного типа, если при этом использовать компоненты, несколько отличающиеся от тех, которые имеются у ныне существующих клеток. В действительности, однако, полного синтеза всех клеточных компонентов не требуется. Структура большинства, если не всех компонентов клетки, определяется нуклеиновыми кислотами. Таким образом, проблема создания новых организмов сводится к синтезу новых типов нуклеиновых кислот и замене ими природных нуклеиновых кислот в определенных клетках.
Метод микрохирургии • С помощью микроманипулятора отдельные части клетки можно удалять, добавлять или каким-то образом видоизменять. Крупную клетку амебы удается разделить на три основных компонента – клеточную мембрану, цитоплазму и ядро, а затем эти компоненты можно вновь собрать и получить живую клетку. Таким путем могут быть получены искусственные клетки, состоящие из компонентов разных видов амеб. • Если принять во внимание, что некоторые клеточные компоненты представляется возможным синтезировать искусственно, то опыты по сборке искусственных клеток могут оказаться первым шагом на пути к созданию в лабораторных условиях новых форм жизни. Поскольку каждый организм развивается из одной единственной клетки, метод получения искусственных клеток в принципе позволяет конструировать организмы заданного типа, если при этом использовать компоненты, несколько отличающиеся от тех, которые имеются у ныне существующих клеток. В действительности, однако, полного синтеза всех клеточных компонентов не требуется. Структура большинства, если не всех компонентов клетки, определяется нуклеиновыми кислотами. Таким образом, проблема создания новых организмов сводится к синтезу новых типов нуклеиновых кислот и замене ими природных нуклеиновых кислот в определенных клетках.
 Метод слияния клеток • Другой тип искусственных клеток может быть получен в результате слияния клеток одного или разных видов. Чтобы добиться слияния, клетки подвергают воздействию вирусных ферментов; при этом наружные поверхности двух клеток склеиваются вместе, а мембрана между ними разрушается, и образуется клетка, в которой два набора хромосом заключены в одном ядре. Можно слить клетки разных типов или на разных стадиях деления. Используя этот метод, удалось получить гибридные клетки мыши и цыпленка, человека и мыши, человека и жабы. Такие клетки являются гибридными лишь изначально, а после многочисленных клеточных делений теряют большинство хромосом либо одного, либо другого вида. Конечный продукт становится, например, по существу клеткой мыши, где человеческие гены отсутствуют или имеются лишь в незначительном количестве. Особый интерес представляет слияние нормальных и злокачественных клеток. В некоторых случаях гибриды становятся злокачественными, в других нет, т. е. оба свойства могут проявляться и как доминантные, и как рецессивные. Этот результат не является неожиданным, так как злокачественность может вызываться различными факторами и имеет сложный механизм.
Метод слияния клеток • Другой тип искусственных клеток может быть получен в результате слияния клеток одного или разных видов. Чтобы добиться слияния, клетки подвергают воздействию вирусных ферментов; при этом наружные поверхности двух клеток склеиваются вместе, а мембрана между ними разрушается, и образуется клетка, в которой два набора хромосом заключены в одном ядре. Можно слить клетки разных типов или на разных стадиях деления. Используя этот метод, удалось получить гибридные клетки мыши и цыпленка, человека и мыши, человека и жабы. Такие клетки являются гибридными лишь изначально, а после многочисленных клеточных делений теряют большинство хромосом либо одного, либо другого вида. Конечный продукт становится, например, по существу клеткой мыши, где человеческие гены отсутствуют или имеются лишь в незначительном количестве. Особый интерес представляет слияние нормальных и злокачественных клеток. В некоторых случаях гибриды становятся злокачественными, в других нет, т. е. оба свойства могут проявляться и как доминантные, и как рецессивные. Этот результат не является неожиданным, так как злокачественность может вызываться различными факторами и имеет сложный механизм.



